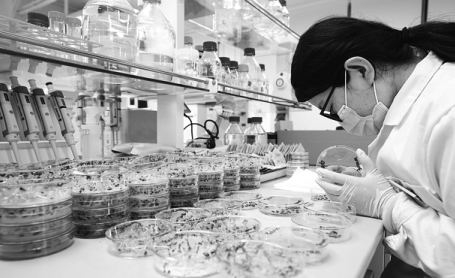

Seed ID technology helps better protect owners' IPR

A new independently developed method to identify seed varieties at the molecular level is being applied to help detect counterfeits and quickly clarify the intellectual property owners of imported germ plasm resources, experts said.
The method, called MNP marker, can obtain identifications for crop varieties with much higher efficiency and 99.98 percent accuracy, said Peng Hai, head of the research team at Jianghan University in Wuhan, Hubei province.
Using the method, a person can identify 1,033 markers of rice cultivars. The efficiency is a thousand times higher than traditional identification methods, Peng told Chutian Metropolis Daily, a news portal based in Hubei.
Last year, Yazhou Bay Seed Laboratory in Sanya, Hainan province, introduced the MNP marker method developed by Peng's team.
The lab was established in May last year to cultivate seed varieties with robust performances and break scientific bottlenecks in the seed industry.
Peng Jun, deputy director of the laboratory, said researchers used the method during molecular testing to clearly identify seed varieties.
"It provided important technical support for confirming and protecting intellectual property rights and will play a role in the global market," he said.
Although China has made achievements in the seed industry in recent years, it still faces challenges cultivating good varieties and solving the homogenization problem of seed resources.
Peng Jun said it may take agronomists more than 10 years to cultivate a variety, but sometimes others make "little modifications" to existing varieties to create counterfeit ones so they can own new IPRs.
"The MNP marker can identify the seed variety and distinguish essentially derived varieties from counterfeits, encouraging scientists' innovation in the seed industry," he said, adding it can authenticate crop varieties including rice, corn, tomato and watermelon.
By using an MNP-fingerprint database, seed breeding companies can decide whether to give up on less innovative varieties and adjust their research to avoid unnecessary investment.
As well as technologies, the revised Seed Law, which took effect on March 1, has also strengthened protection of new plant varieties and seed-related intellectual property rights, according to Yang Heqing, an official from the National People's Congress Standing Committee's Legislative Affairs Commission.
The revised law establishes a system of essentially derived varieties that are distinct from, but retain the basic characteristics of, the original varieties.
The law clarifies that though authorization and new plant variety rights can be sought for essentially derived varieties, the owners of the original varieties should agree with and charge for their commercial use, Yang said.
The punishment for those who intentionally infringe on the rights of holders of new plant varieties has been increased to further protect the legitimate rights of the IPR owners, he added.
Cao Yin contributed to this story.
Today's Top News
- New Year's address inspiring for all
- Xi congratulates Science and Technology Daily on its 40th anniversary
- Xi congratulates Guy Parmelin on assuming Swiss presidency
- China Daily launches 'China Bound'
- Manufacturing rebounds in December
- PLA wraps up military drills around Taiwan






























